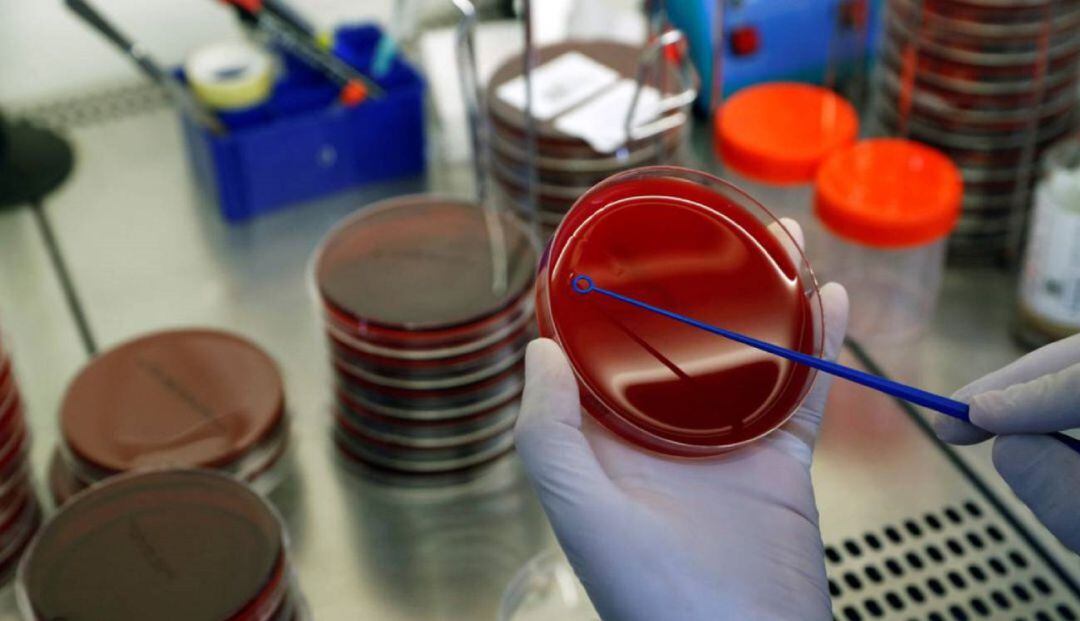
Un análisis en un laboratorio.

Treinta casos más y un nuevo hospitalizado en la comarca por Covid19
El Campo de Gibraltar ya supera los 1.900 contagios desde el inicio de la pandemia

Un análisis en un laboratorio. / Reuters
La Consejería de Salud y Familias ha confirmado que el Campo de Gibraltar vuelve a registrar una treintena de nuevos casos por coronavirus en la jornada de este viernes. 21 de ellos se localizan otra vez en Algeciras, que sigue siendo la más castigada en la comarca. Además, Tarifa suma cuatro contagios más, Los Barrios dos y La Línea, Jimena y San Roque, uno que establecen un total de 1.907 positivos.
Por su parte, se contabilizan 39 curados más (1.172) y un nuevo hospitalizado (159). No hay variaciones en los fallecimientos (45) ni en los números de pacientes en la UCI (26).
Por municipios, Algeciras registra 831 y 25 fallecidos seguido por La Línea con 526 y 5 muertes, San Roque (178-1), Los Barrios (132-7), Tarifa (184-6), Jimena (30-1), Castellar (13-0) y San Martín del Tesorillo (13-0).
DOS NUEVOS CONTAGIOS EN CENTROS
Además, siguen produciéndose contagios en centros educativos y así, tenemos que hablarles del aislamiento de dos clases en el Instituto Ventura Morón en un aula de FP Básica así como en el colegio Huerta de la Cruz de Algeciras.




